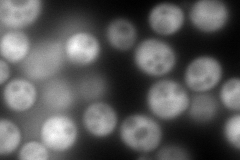
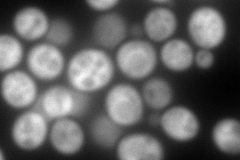
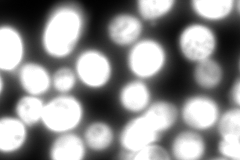

View description
Enolase II, a phosphopyruvate hydratase that catalyzes the conversion of 2-phosphoglycerate to phosphoenolpyruvate during glycolysis and the reverse reaction during gluconeogenesis; expression is induced in response to glucose
Localization:
Intensity:
Fold change:
Significance:
-
C’ GFP library in SD

cytosol3261.82 -
N' NOP1pr-GFP in SD
cytosol631.578 -
N' TEF2pr-mCherry in SD
cytosol502.3 -
N' NATIVEpr-GFP in SD
cytosol2673.17 -
N' TEF2pr-VC and Cyto-VN in SD

cytosol88.5702 -
C’ GFP library in SD+DTT

cytosol3267.781No -
C’ GFP library in SD+H2O2

cytosol3267.781No -
C’ GFP library in Starvation Media

cytosol3261.821No -
C’ GFP library on the background of Pup2-DaMP

cytosol -
C’ GFP library on the background of CCT mutant

cytosol3726.211.14237No
